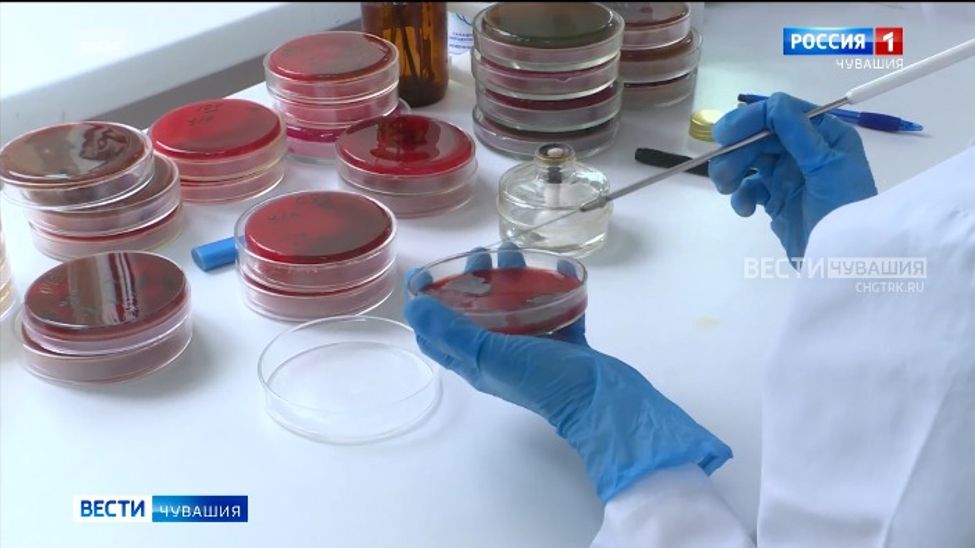
Заболеваемость пневмонией в Чувашии за неделю выросла на 12%

грипп и орви

Об эпидситуации по заболеваемости ОРВИ в республике рассказал региональный Роспотребнадзор.

На 2-й неделе 2024 года в республике зарегистрировано 7394 случая ОРВИ, показатель заболеваемости составил 630,3 на 100 тысяч населения, что в 1,5 раза выше среднемноголетнего уровня.

По сравнению с последней неделей 2023 года заболеваемость ОРВИ по республике снизилась в 4,1 раза. А уровень заболеваемости ОРВИ совокупного населения региона ниже эпидпорога аж в 5 раз.

Более 400 человек переболели в прошлом году коронавирусной инфекцией в Ядринском муниципалитете. В основном болезнь лечили в амбулаторных условиях, тяжёлых случаев не зафиксировано.

Уровень заболеваемости ОРВИ совокупного населения Чувашской Республики выше эпидпорога на 50,3%, отмечают в Роспотребнадзоре Чувашии.

Врачи отмечают традиционный рост заболеваемости острыми респираторными инфекциями.
В республике, и особенно в её столице регистрируется рост заболеваемости ОРВИ, гриппом и пневмонией. Об этом шла речь на совещании в городской администрации.

На 48-й неделе в Чувашии зарегистрировано 6863 случая ОРВИ, показатель заболеваемости составил 585,0 на 100 тысяч населения, что на 2,7% ниже среднемноголетнего уровня.

На 47-й неделе в республике зарегистрировано 5774 случая ОРВИ, показатель заболеваемости составил 492,2 на 100 тысяч населения, что на 3,8% ниже среднемноголетнего уровня, рассказали в региональном Роспотребнадзоре.

На 44-й неделе в республике зарегистрировано 3885 случаев ОРВИ, показатель заболеваемости составил 324,2 на 100 тысяч населения, что на 5,1% ниже среднемноголетнего уровня, сообщили в региональном Роспотребнадзоре.

На 43-й неделе в республике зарегистрировано 4654 случая ОРВИ, показатель заболеваемости составил 388,3 на 100 тысяч населения, что на 16,2% ниже среднемноголетнего уровня, сообщил республиканский Роспотребнадзор.

Для иммунизации взрослого населения против гриппа в рамках национального календаря профилактических прививок на аптечную базу ГУП Чувашской Республики «Фармация» поступило 216080 доз отечественной вакцины «Совигрипп».

За прошедшую неделю в Чувашии зарегистрировано 5346 случаев заболевания ОРВИ, показатель заболеваемости составил 446,1 на 100 тысяч населения, что на 3,2% ниже среднемноголетнего уровня.

К слову, привилась от гриппа почти четверть населения, сообщил региональный Роспотребнадзор.

Роспотребнадзор уже не первую неделю регистрирует рост заболеваемости сезонными простудными заболеваниями, а также ковидом.

На 38-й неделе в республике зарегистрировано 7507 случаев заболевания ОРВИ, показатель заболеваемости составил 626,4 на 100 тысяч населения, что на 3,4% выше среднемноголетнего уровня.

Об эпидситуации по заболеваемости ОРВИ в Чебоксарах говорили сегодня на планерке в столичной мэрии. По словам заместителя руководителя Управления Роспотребнадзора по Чувашии Веры Головач, в Чебоксарах зарегистрировано 75% заболевших ОРВИ — это почти пять с половиной тысяч случаев.

Сегодня на утренней планерке у главы города Чебоксары Евгения Кадышева и главы администрации Дениса Спирина заслушана информация об эпидемиологической обстановке в столице по заболеваемости гриппом и ОРВИ.

Ковид опять наступает. Только за минувшую неделю в стационары был госпитализирован 31 пациент.

В Городской клинической больнице №1 продолжается прививочная кампания против гриппа. Вакцинация проводится во всех прививочных кабинетах поликлиник. Кроме того, для удобства населения в общественные места города выезжает мобильный прививочный пункт.

Заслуженный работник сельского хозяйства Российской Федерации и Чувашской Республики, кавалер ордена "Знак Почёта" Платон Давыдов руководил совхозом "Ударник" Моргаушского района более 30 лет и поднял его на высокий уровень. Именно на таких великих тружениках, настоящих патриотах держится сельское хозяйство, они являются примером для новых поколений.

Авторский фильм Алексея Енейкина, посвященный 95-летию колхоза «Броневик» Вурнарского МО, знакомит с историей коллективного хозяйства, которое создавали жители трех деревень: Хумуши, Ослаба и Кивьялы. Они смогли сохранить свое хозяйство даже в самые трудные 90-е. Сейчас «Броневик» работает над увеличением поголовья КРС, возрождает коневодство и является единственным колхозом в Калининском территориальном отделении муниципального округа.

Герой очередного фильма из серии "Халӑх ывӑлӗ - Ирӗк Килтӗш (Валерий Краснов). Художник с высшим образованием, он не только пишет картины, но и сочиняет стихи, музыку, сам же исполняет свои песни на гитаре. Постоянным местом жительства Валерий выбрал родную деревню. Для него родительский дом - центр вселенной: там, где художник самодостаточен и счастлив, он создаёт все свои произведения.

Документальный фильм Алексея Енейкина «Несӗлсен ҫулӗпе» (По следам предков — сувар) посвящен научно-популярным экспедициям на землях наших прародителей — суваро-булгар: в Чувашии, Татарстане, Башкирии, Челябинской и Тюменской областях, в республиках Алтай и Дагестан, в Азербайджане.

Финал первого республиканского конкурса детской патриотической песни "Россия голосами детей". Конкурс приурочен к 80-летию Победы, Году Победы и патриотизма в Чувашии. На конкурс поступило более 200 работ из Чувашии, а также из Ульяновской и Свердловской областей. Проведен при поддержке Министерства культуры, Министерства образования и Общественной палаты республики.

В очередном авторском телеочерке цикла "Халӑх ывӑлӗ" рассказывается о многолетней творческой деятельности Николая Григорьева - народного артиста РСФСР и Чувашии, лауреата государственной премии РСФСР имени К. Станиславского.

Очередной фильм из серии «Халӑх ывалӗ» рассказывает о творчестве народного мастера, резчика по дереву Петра Мазуркина

Как проходил настоящий «Уяв» в старину? Какие песни и танцы украшали праздничные хороводы наших предков — потомков древних суваро-булгар? Об этом в авторском фильме Алексея Енейкина рассказывают жители Аксубаевского района Республики Татарстан.

Михаил Долгов добился высоких показателей в в сельском хозяйстве республики и был удостоен звания "Герой Социалистического труда". Благодаря ему жители Чувашии начали массово выращивать севок и по сегодняшний день удерживают лидерство в производстве лука.

Авторский фильм из цикла "Халӑх ывӑлӗ" Валерий Яковлев

Нефтеюганский район Ханты- Мансийского автономного округа готовится принять 19-й по счету Международный турнир по вольной борьбе. Его организатор - выходец из Чувашии, уроженец Яльчикского МО Владимир Семёнов. Об истории состязаний, его участниках и почетных гостях - в фильме наших коллег из Нефтеюганска.

Авторский фильм Алексея Енейкина «Пурӑнатпӑр-ха, тӑван» знакомит с жизнью кемеровских чувашей.

Серия роликов о том, как изменились знаменитые места столицы Чувашии.

Фильм Алексея Енейкина о сибирских чувашах «Сывӑ-и, тайгари ентешӗм?» знакомит с земляками из далекого Красноярского края, рассказывает об их жизни и традициях, о том, как важно знать историю предков, беречь родной язык и культуру древнего суваро-булгарского народа.

Герой очередного телеочерка из цикла "Халӑх ывӑлӗ" - композитор, баянист, певец, заслуженный деятель искусств Чувашской Республики Анатолий Никитин. Автор более семисот популярных песен для всех возрастов, руководитель ансамбля "Янташ" вместе с супругой воспитал целые поколения чувашских эстрадных певцов.

Авторский телеочерк из цикла "Халӑх ывӑлӗ" Николай Егоров Эфир от 11.04.2024

Герой телеочерка из цикла "Халӑх ывӑлӗ" - Народный художник Чувашской Республики Станислав Юхтар. В центре внимания - творчество мастера, ярко проявившего себя как этнофутурист и поражающего постоянными поисками, новизной в изображении мира.

Герой телеочерка из цикла "Халӑх ывӑлӗ" Юрий Артемьев - литературный критик, доктор филологических наук, профессор. Он долгие годы преподавал в Чувашском государственном университете имени И.Н.Ульянова, был заведующим кафедрой русской и зарубежной литературы.

К 100-летию со дня рождения народной артистки СССР Веры Кузьминичны Кузьминой.

Знаменитое детище Чувашии и главный экспонат Чувашского национального музея на полгода переехал в Москву. Сейчас вышитую карту разместили в одном из павильонов ВДНХ. К слову, впервые вышитая карта из Чувашии была на этой выставке в 1939 году.

Заслуженный художник Российской Федерации, Народный художник Чувашии Анатолий Рыбкин уже полвека живёт в Санкт-Петербурге, часто бывает в творческих командировках далеко за пределами страны, но самое святое место, микрокосм для мастера кисти - малая родина. Тяга родного очага - сильнее всего, и он из города на Неве постоянно возвращается в свою деревушку на берегу Волги. Папин сад, мамино благословение помогают ему творить. *Фильм на чувашском языке.

В октябре 2021 года у Чувашской Республики появилась необычная карта - вышитая: 21 район, 9 городов, река Волга, поля, леса - получилось и информативно, и красиво. Ей суждено было стать началом большого общероссийского проекта.

VIII Республиканский фестиваль музыки «Молодые таланты»

Чувашская государственная академическая симфоническая капелла. Программа «По страницам Шекспира - Пушкина - Гоголя»

Чувашская государственная академическая симфоническая капелла представит новую концертную программу «В. Высоцкий. На нейтральное полосе». В программе: «Лирическая», «Баллада о борьбе», «Дом хрустальный», «Утренняя гимнастика». Художественный руководитель и главный дирижер симфонической капеллы — Морис Яклашкин.

Подведение итогов культурной жизни республики за 2022 год.

III-й Международный фестиваль "Созвездие земляков"

2023 год в республике объявлен Годом счастливого детства. 4 октября главной темой 2-х часового эфира стало обеспечение благополучного и безопасного детства, предоставление детям равных возможностей для всестороннего развития.

Концерт «Симфо-фолк – музыка на все времена»

В Чебоксарах состоялся IX Всероссийский фестиваль теле- и радиопрограмм "Человек и вера". Впервые фестиваль прошел в 2014 году в Тобольске – духовной столице Сибири. Затем его принимали Казань, Вологда, Псков, Тверь. "Человек и вера" - это уникальное явление в культурной и духовной жизни России. Каждый год журналисты из разных уголков страны отыскивают интересные факты, выдвигают свои версии исторических событий, рассказывают о людях, посвятивших жизнь России, Богу, милосердию. В этом году в адрес оргкомитета было прислано более 170 работ. 17 из них попали в финал конкурса.

Автор Елена Гальперина, режиссер Илья Коршунов

Всероссийский Марафон молодежной патриотической песни в апреле 2022 запустила ВГТРК. На региональном этапе на сайт ГТРК «Чувашия» поступило 45 видеороликов с самыми разными песнями о Родине от солистов и творческих коллективов: были и народные, и советская классика, и военный репертуар, были Кинчев, Тальков, Цой и Трофим.

VII Республиканский фестиваль музыки «Молодые таланты» Чувашская государственная филармония. 27 апреля 2022 года

Концерт августы Уляндиной

Концерт «Золотые шлягеры кино. Петербург Андрея Перова» в исполнении БУ «Симфоническая капелла» Минкультуры Чувашии.

Торжественный вечер, посвященный 95-летию радио и 60-летию ТВ

Большой концерт, посвященный 95-летнему юбилею радио ГТРК "Чувашия"

Интернет-проект про перемены — к лучшему. Дизайн, переделка, перестановка, тестирование материалов для ремонта и умных гаджетов. Съемки в реальных условиях с людьми, экспертами и котиками.

Проект ГТРК «Чувашия» посвящен 75-летию Великой Победы. Собран из цикла сюжетов и роликов, которые журналисты компании готовили совместно с нашими зрителями и пользователями соцсетей компании. Это наш общий проект и общий праздник.

К юбилейной дате - 100-летию образования Чувашской автономной области, ГТРК "Чувашия" создает цикл роликов о важнейших вехах становления республики.




















































